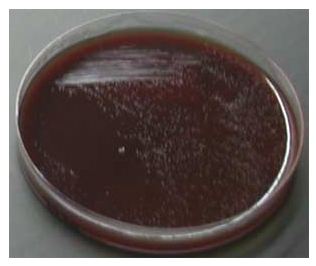

Elle croît lentement (3 à 4 jours minimum) et exige des conditions de culture particulières (micro-aérophile) et des milieux de culture additionnés de sang, de sérum ou de suppléments d’enrichissement (Flandrois,1997) tels que la gélose PYL (sélective pour H.pylori) ou Columbia additionnée de sang. Les colonies sont petites (0.5 mm) ou en nappes brillantes et non hémolytiques.* (Figure n°6)
Figure n°6 : Aspect des colonies de H.pylori sur gélose Columbia au sang frais*
* : http://bacterioweb.univ-fcomte.fr/bibliotheque/remic/23-Helic.pdf